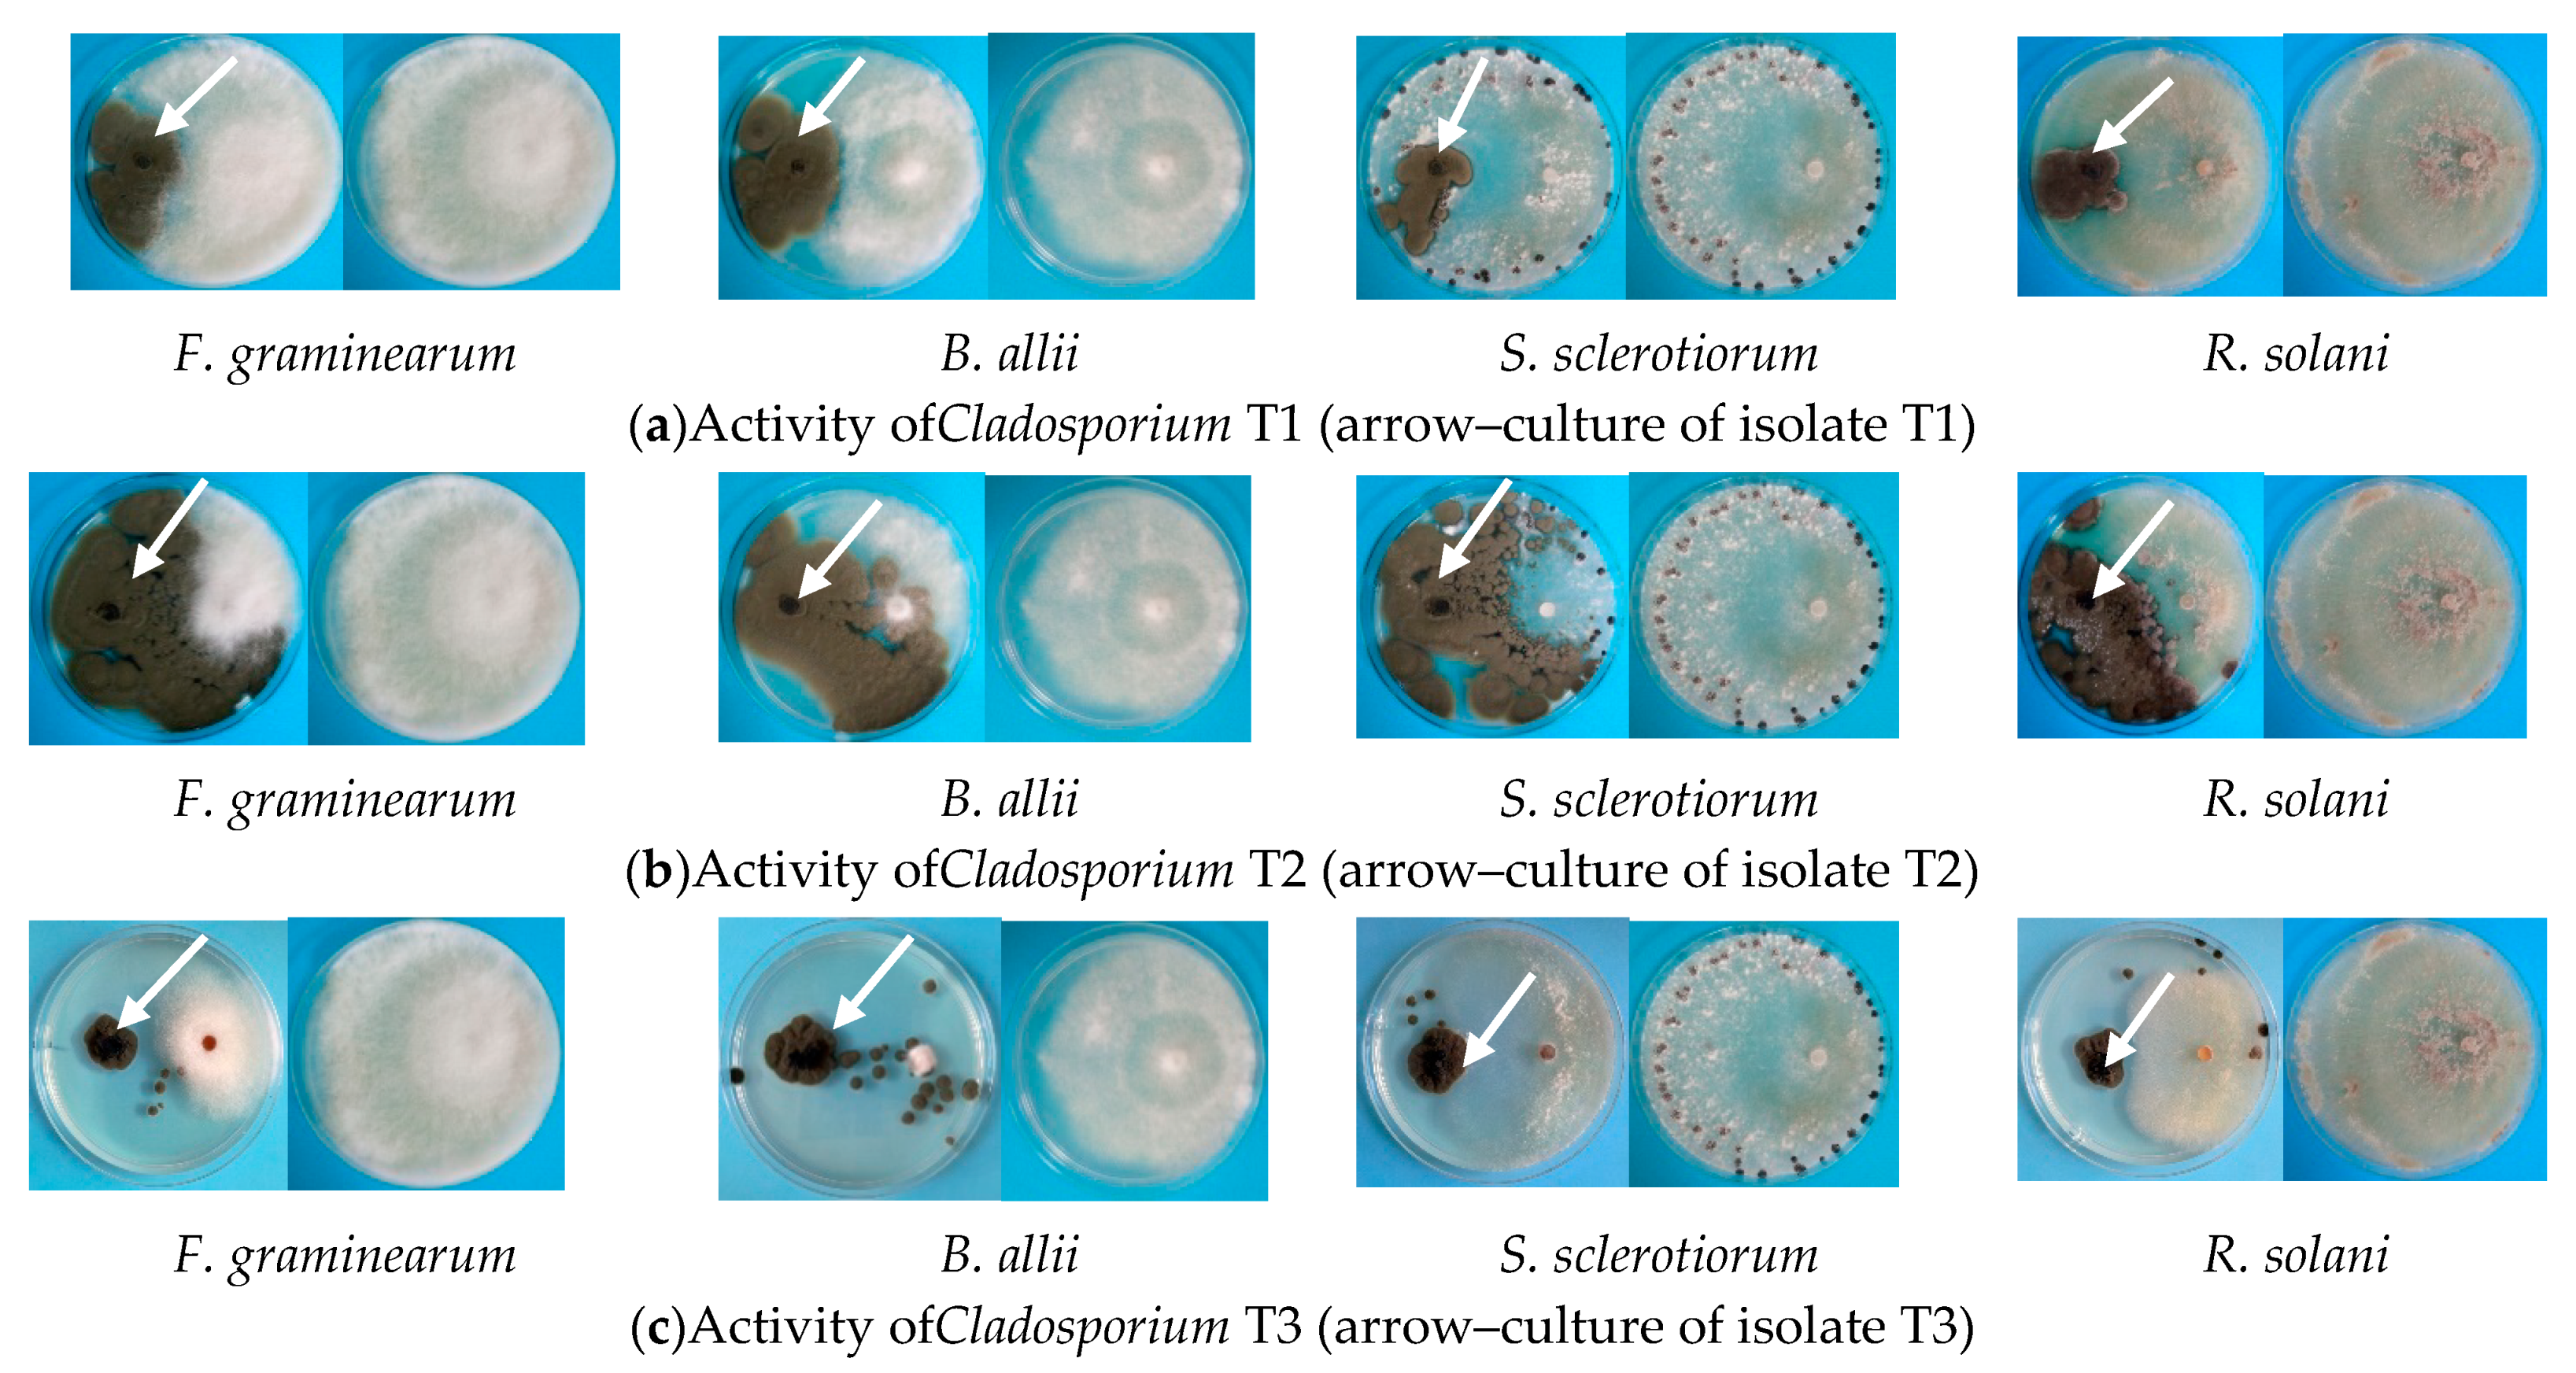
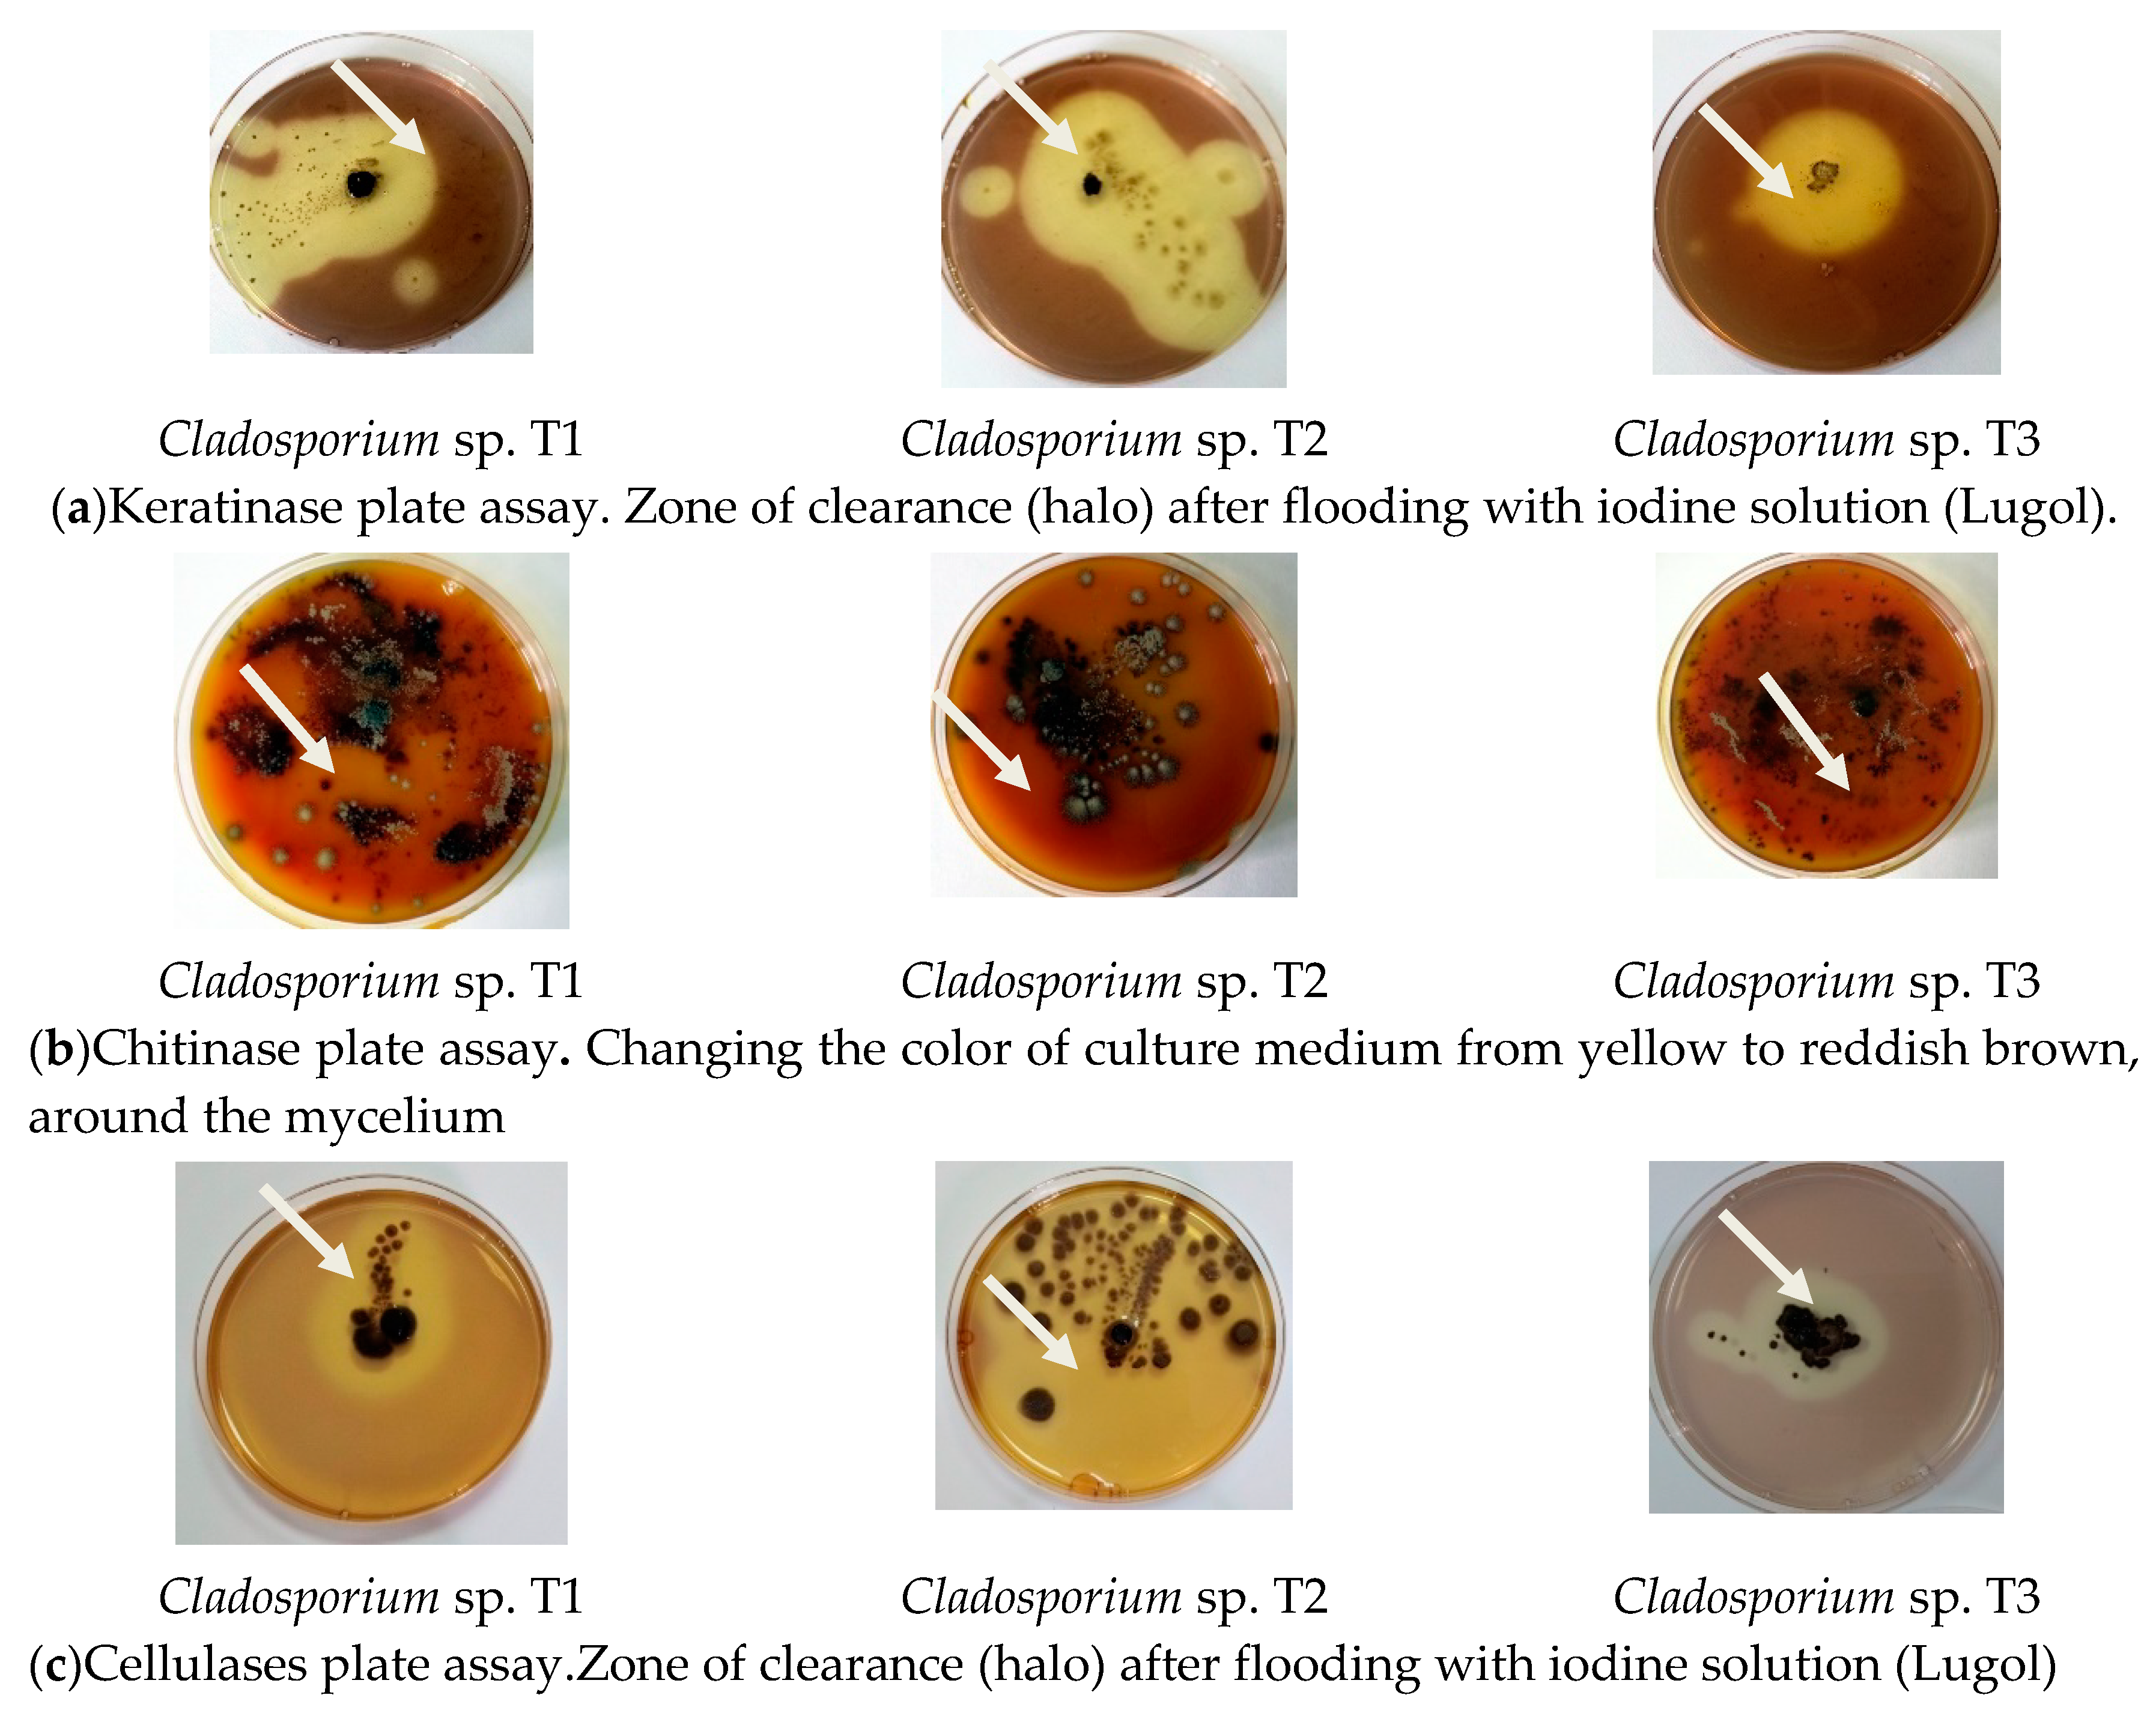
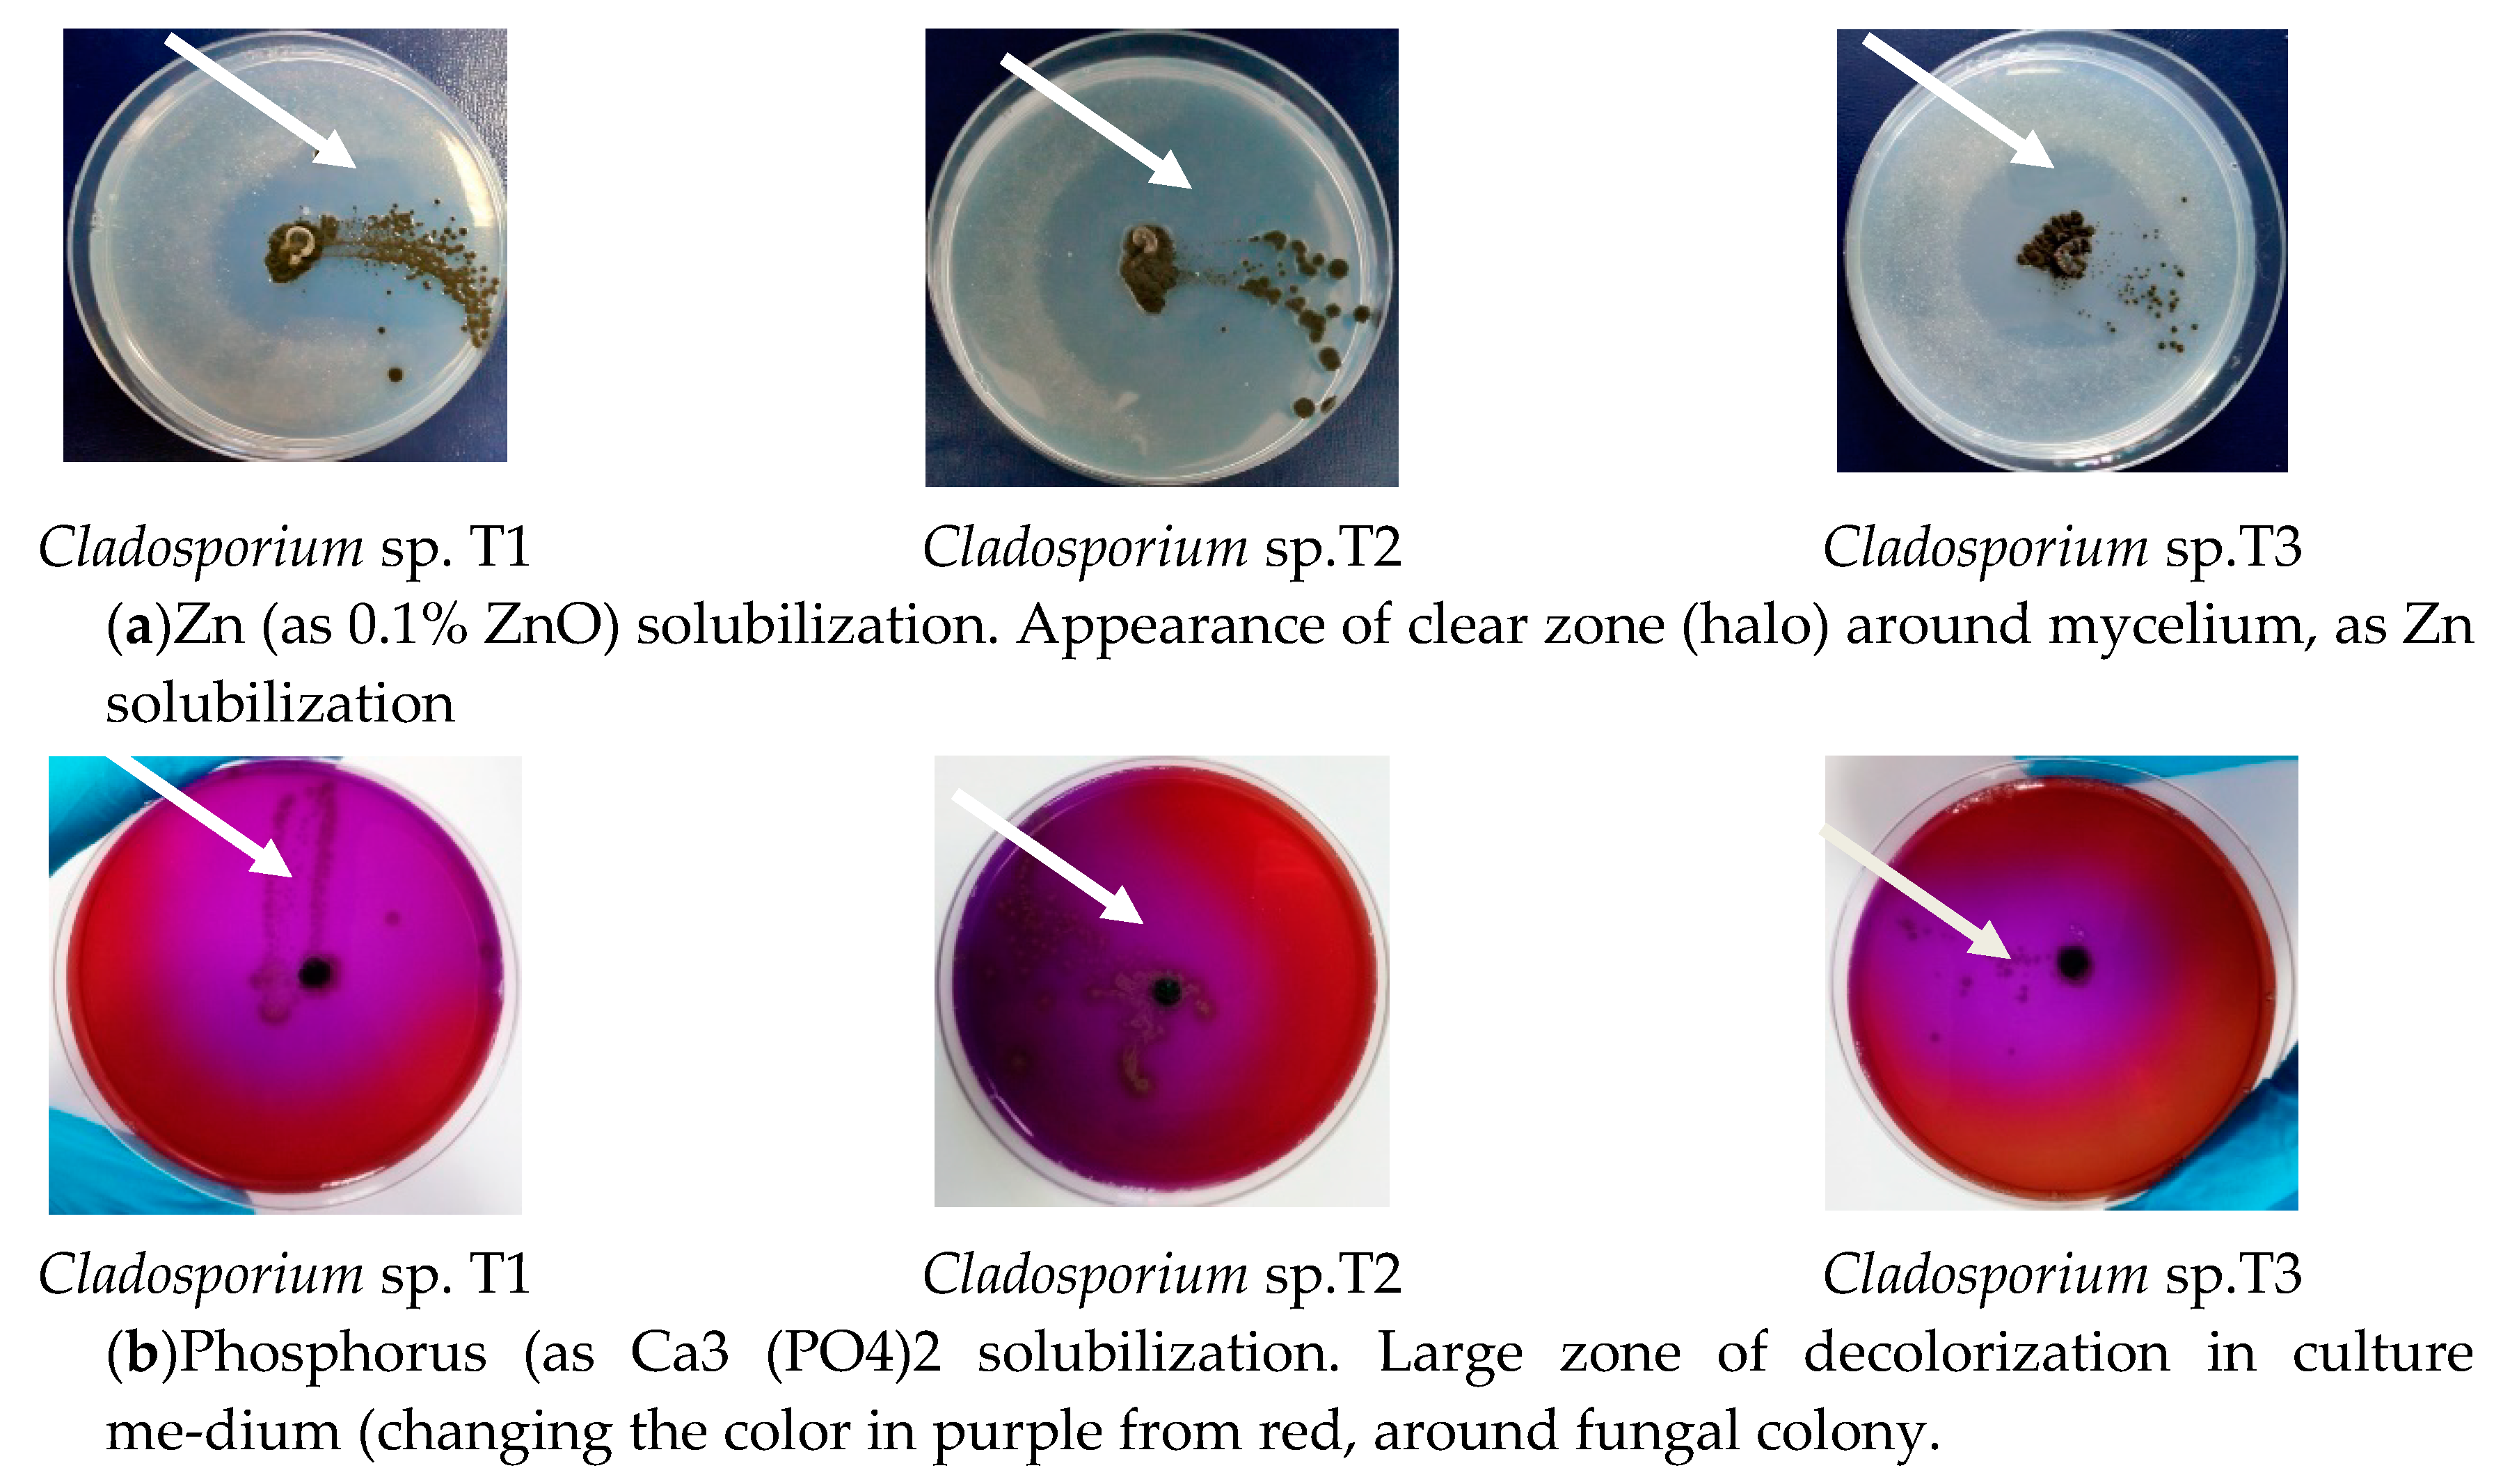

Cladosporium sp. Isolate as Fungal Plant Growth Promoting Agent
Abstract
1. Introduction
2. Materials and Methods
2.1. Microorganism
2.2. Keratin Substrate
2.3. Fungal Cultivation for Protein Hydrolysates (PHs) Preparation
2.4. Antagonism versus Plants Pathogens
2.5. Evaluation of Tomato Growth Promotion by Volatiles Produced by Isolates
2.6. Enzymatic Activities
2.7. Colorimetric Assay for 3-Indole Acetic Acid (IAA) Production
2.8. In Vitro Zinc Solubilization Assessment Using Plate Assay
2.9. In Vitro Phosphate Solubilization Assessment Using Plate Assay
2.10. Nitrogen Content of Protein Hydrolysates
2.11. Test In Vivo for the Capacity to Promote Tomato Seedlings Growth (Pot Experiments)
2.12. Statistical Analysis
3. Results
3.1. Antagonism versus Plant Pathogens
3.2. Effects of Volatiles Secreted by Cladosporium Isolates
3.3. Secretion of Hydrolytic Enzymes
3.4. IAA Production
3.5. Capacity of Zinc and Phosphorus Solubilising
3.6. Nitrogen Content
3.7. Pot Experiments with Tomato Seedlings Treated with Protein Hydrolysates from Cladosporium Cultures
3.8. Statistic Analysis
4. Discussion
5. Conclusions
Author Contributions
Funding
Acknowledgments
Conflicts of Interest
References
- Archard, P.; Genschik, P. Releasing the brakes of plant growth: How GAs shutdown DELLA proteins. J. Exp. Bot. 2009, 60, 1085–1092. [Google Scholar] [CrossRef] [PubMed]
- Hamayun, M.; Khan, S.A.; Ahmad, N.; Tang, D.-S.; Kang, S.-M.; Na, C.-I.; Sohn, E.-Y.; Hwang, Y.-H.; Shin, D.-H.; Le, B.-H.; et al. Cladosporium sphaerospermum as a new plant growth-promoting endophyte from the roots of Glycine max (L.) Merr. World J. Microbiol. Biotechnol. 2009, 25, 627–632. [Google Scholar] [CrossRef]
- Hamayun, M.; Khan, S.A.; Khan, A.L.; Rehman, G.; Kim, Y.H.; Iqbal, I.; Hussain, J.; Sohn, E.-Y.; Lee, I.-J. Gibberellin production and plant growth promotion from pure cultures of Cladosporium sp. MH-6 isolated from cucumber (Cucumis sativus L.). Mycologia 2010, 102, 989–995. [Google Scholar] [CrossRef] [PubMed]
- Almatar, M.; Makky, E.A. Cladosporium cladosporioides from the perspectives of medical and biotechnological approaches. 3 Biotech 2016, 6, 4. [Google Scholar] [CrossRef]
- Uma, C.; Gomathi, D.; Ravikumar, G.; Kalaiselvi, M.; Palaniswamy, M. Production and properties of invertase from a Cladosporium cladosporioides in SmF using pomegranate peel waste as substrate. Asian Pac. J. Trop. Biomed. 2012, 2, S605–S611. [Google Scholar] [CrossRef]
- Rashmi, R.; Siddalingamurthy, K.R. Cladosporium tenuissiumum—A new producer of xyloglucanase –specific endoglucanase. Int. J. Pharm. Bio. Sci. 2013, 4, 1291–1297. [Google Scholar]
- Hariharan, P.; Chandrashekhar, N.; Pooja Vajpaye, S.; Srinivasa, K. Production, purification and characterization of thrombolytic enzyme from Cladosporium spp. through solid state fermentation. Int. J. Eng. Res. Technol. 2014, 3, 585–589. [Google Scholar]
- Guan, G.Q.; Zhao, P.X.; Zhao, J.; Wang, M.J.; Huo, S.H.; Cui, F.J.; Jiang, J.X. Production and Partial Characterization of an Alkaline Xylanase from a Novel Fungus Cladosporium oxysporum. Hindawi Publishing Corporation. BioMed Res. Int. 2016, 4575024. [Google Scholar] [CrossRef]
- Jakovljevic, V.D.; Vrvic, M.M. Potential of pure and mixed cultures of Cladosporium cladosporioides and Geotrichum candidum for application in bioremediation and detergent industry. Saudi J. 2018, 25, 529–536. [Google Scholar] [CrossRef] [PubMed]
- Ademakinwa, N.A.; Agboola, F.K. Production of Laccase by Auerobasidium pullulans and Cladosporium werneckii under optimized conditions: Applications in decolourization of textile dye. Res. Rev: J. Microbiol. Biotechnol. 2014, 3, 32–40. [Google Scholar]
- Nwadiaro, P.; Ogbonna, A.; Ponchang, W.; Adekojo, D. Keratinolytic activity of Cladosporium and Trichoderma species isolated from barbers’ landfill. Int. J. Biosci. 2015, 6, 104–115. [Google Scholar]
- Cavello, I.A.; Chesini, M.; Hours, R.A.; Cavalitto, S.F. Study of the production of alkaline keratinases in submerged cultures as an alternative for solid waste treatment generated in leather technology. J. Microbiol. Biotechnol. 2013, 23, 1004–1014. [Google Scholar] [CrossRef] [PubMed]
- Xu, L.; Geelen, D. Developing Biostimulants from Agro-Food and Industrial By-Products. Front. Plant Sci. 2018, 9, 1567. [Google Scholar] [CrossRef] [PubMed]
- Vasconcelos, A.C.F.; Chaves, L.H.G. Biostimulants and Their Role in Improving Plant Growth under Abiotic Stresses. IntechOpen 2019. [Google Scholar] [CrossRef]
- Rouphael, Y.; Colla, G. Editorial: Biostimulants in Agriculture. Front. Plant. Sci. 2020, 11, 40. [Google Scholar] [CrossRef]
- Bulgari, R.; Franzoni, G.; Ferrante, A. Biostimulants Application in Horticultural Crops under Abiotic Stress Conditions. Agronomy 2019, 9, 306. [Google Scholar] [CrossRef]
- Menon, S.; Savur, B.; Kasat, D.; Movani, U.; Singh, S.; Rane, M. Management and utilization of Keratin Waste–A review. Int. J. Adv. Res. Ideas Innov. Technol. 2020, 6, 511–515. [Google Scholar]
- Šafari, R.; Zemlji, L.F.; Novak, M.; Dugonik, B.; Bratina, B.; Gubeljak, N.; Bolka, S.; Strnad, S. Preparation and Characterisation of Waste Poultry Feathers Composite Fibreboards. Materials 2020, 13, 4964. [Google Scholar] [CrossRef]
- Seidavi, A.R.; Zaker-Esteghamati, H.; Scanes, C.G. Present and potential impacts of waste from poultry production on the environment. Worlds Poult. Sci. J. 2019, 75, 29–42, Cambridge University Press. [Google Scholar] [CrossRef]
- Kodak, S.; Gharge, T.; Chavan, V.; Sibi, G. Microbial Degradation of Poultry Feather Wastes under the Influence of Temperature and pH—A Review. Int. J. Environ. Sci. Nat. Res. 2019, 21, 556063. [Google Scholar] [CrossRef]
- He, Z.; Sun, R.; Tang, Z.; Bu, T.; Wu, Q.; Li, C.; Chen, H. Biodegradation of Feather Waste Keratin by the Keratin-Degrading Strain Bacillus subtilis 8. J. Microbiol. Biotechnol. 2018, 28, 314–322. [Google Scholar] [CrossRef]
- Joardar, J.C.; Rahman, M.M. Poultry feather waste management and effects on plant growth. Int. J. Recycl. Org. Waste Agric. 2017, 7, 183–188. [Google Scholar] [CrossRef]
- Brandelli, A.; Sala, L.; Kalil, J. Microbial enzymes for bioconversion of poultry waste into added-value products. Food Res. Int. 2015, 73, 3–12. [Google Scholar] [CrossRef]
- Ghaffar, I.; Imtiaz, A.; Hussain, A.; Arshad Javid, A.; Jabeen, F.; Akmal, M.; Qaz, J.I. Microbial production and industrial applications of keratinases: An overview. Int. Microbiol. 2018, 21, 163–174. [Google Scholar] [CrossRef]
- Akpor, O.B.; Odesola, D.E.; Thomas, R.E.; Oluba, O.M. Chicken feather hydrolysate as alternative peptone source for microbial cultivation. F1000Research 2019, 7, 1918. [Google Scholar] [CrossRef] [PubMed]
- Islam, M.A.; Nain, Z.; Alam, M.K.; Banu, N.A.; Islam, M.R. In vitro study of biocontrol potential of rhizospheric Pseudomonas aeruginosa against Fusarium oxysporum f. sp. Cucumerinum. Egypt. J. Biol. Pest Control 2018, 28, 90. [Google Scholar] [CrossRef]
- Li, Z.T.; Wojciech, J.J.; Zongrang, L.; Callahan, A.M.; Breyn, E.E.; Wayne, J.M.; Chris, D. Exposure in vitro to an Environmentally Isolated Strain TC09 of Cladosporium sphaerospermum Triggers Plant Growth Promotion, Early Flowering, and Fruit Yield Increase. Front. Plant. Sci. 2019, 9, 1959. [Google Scholar] [CrossRef]
- Agrawal, T.; Kotasthane, A.S. Chitinolytic assay of indigenous Trichoderma isolates collected from different geographical locations of Chhattisgarh in Central India. SpringerPlus 2012, 1, 73. [Google Scholar] [CrossRef] [PubMed]
- Yoon, J.H.; Park, J.E.; Dong, Y.S.; Hong, S.B.; Ko, S.J.; Kim, S.H. Comparison of dyes for easy detection of extracellular cellulases in fungi. Mycobiology 2007, 35, 21–24. [Google Scholar] [CrossRef] [PubMed][Green Version]
- Lateefa, A.; Adelerea, I.A.; Gueguim-Kana, B.E.B. Bacillus safensis LAU 13: A new source of keratinase and its multi-functional biocatalytic applications. Biotechnol. Biotechnol. Equip. 2015, 29, 5463. [Google Scholar] [CrossRef]
- Gordon, S.A.; Weber, R.P. Colorimetric estimation of indole acetic acid. Plant Physiol. 1951, 26, 192–195. [Google Scholar] [CrossRef]
- Gutierrez, C.K.; Matsuy, G.Y.; Lincoln, D.E.; Lovel, C.R. Production of the phytohormone indole-3 acetic acid by the estuarine spesies of the genus Vibrio. Appl. Environ. Microbiol. 2009, 75, 2253–2258. [Google Scholar] [CrossRef]
- Sharma, S.K.; Sharma, M.P.; Ramesh, A.; Joshi, O.P. Characterization of Zinc-Solubilizing Bacillus Isolates and their Potential to Influence Zinc Assimilation in Soybean Seeds. J. Microbiol. Biotechnol. 2012, 22, 352–359. [Google Scholar] [CrossRef]
- Vazquez, P.; Holgui, G.; Puente, M.E.; Lopez-Cortes, A.; Bashan, Y. Phosphate-solubilizing microorganisms associated with the rhizosphere of mangroves in a semiarid coastal lagoon. Biol. Fertil. Soils 2000, 30, 460–468. [Google Scholar] [CrossRef]
- Guo, W.S.; Ren, L.P.; Zhou, Z.M.; Meng, Q.X. Difference of nitrogen contents determined by the combustion and Kjeldahl method in response to nitrate nitrogen in some feedstuffs. J. Anim. Feed Sci. 2007, 16 (Suppl. 2), 178–183. [Google Scholar] [CrossRef]
- Cavello, I.A.; Crespo, J.M.; García, S.S.; Zapiola, J.M.; Luna, M.F.; Cavalitto, S.F. Plant growth promotion activity of keratinolytic fungi growing on a recalcitrant waste known as (hair waste). Biotechnol. Res. Int. 2015, 952921. [Google Scholar] [CrossRef]
- Lee, S.; Yap, M.; Behringer, G.; Hung, R.; Bennett, J.W. Volatile organic compounds emitted by Trichoderma species mediate plant growth. Fungal Biol. Biotechnol. 2016, 3, 7. [Google Scholar] [CrossRef] [PubMed]
- Torres, D.E.; Rojas-Martinez, R.I.; Zavaleta-Mejia, E.; Guevara-Fefer, P.; Marquez-Guzman, G.J.; Perez-Martinez, C. Cladosporium cladosporioides and Cladosporium pseudocladosporioides as potential new fungal antagonists of Puccinia horiana Henn., the causal agent of chrysanthemum white rust. PLoS ONE 2017, 12, e0170782. [Google Scholar] [CrossRef] [PubMed]
- Wang, X.; Radwan, M.; Tarawneh, A.; Gao, J.; Wedge, D.; Rosa, L.; Cutler, H.G.; Cutler, S.J. Antifungal activity against plant pathogens of metabolites from the endophytic fungus Cladosporium cladosporioides. J. Agric. Food Chem. 2013, 61, 4551–4555. [Google Scholar] [CrossRef]
- Moricca, S.; Ragazzi, A.; Mitchelson, K.R.; Assante, G. Antagonism of the two needle pine stem rust fungi Cronartium flaccidum and Peridermium pini by Cladosporium tenuissimum in vitro and in planta. Phytopathology 2001, 91, 457–468. [Google Scholar] [CrossRef] [PubMed]
- Moricca, S.; Ragazzi, A.; Assante, G. Biocontrol of Rust Fungi by Cladosporium tenuissimum. In Rust Diseases of Willow and Poplar; A4913:AMA:Pei:First Proofs: 17-Nov-2004; Pei, M.H., McCracken, A.R., Eds.; ©CAB International: Wallingford, UK, 2005; pp. 213–229. [Google Scholar] [CrossRef]
- Chalfoun, S.M. Biological control and bioactive microbial metabolites: A coffee quality perspective. Cienc. Agrotec. 2010, 34, 1071–1085. [Google Scholar] [CrossRef]
- Islam, T.; Gupta, D.R.; Surovy, M.Z.; Mahmud, N.U.; Mazlan, N. Identification and application of a fungal biocontrol agent Cladosporium cladosporioides against Bemisia tabaci. Biotechnol. Biotechnol. Equip. 2019, 33, 1698–1705. [Google Scholar] [CrossRef]
- Acosta, M.B.R.; De Santa Inez, D.C.; Balieiro, L.F.; Mano, E.T.; da Silva, L.F. Hydrolytic enzymes (DNAses, lipases and proteases) secreted by Cladosporium cladosporioides isolated from soil and its potential application in biotechnology. Rev. Soc. Ven. Microbiol. 2017, 37, 61–65. [Google Scholar]
- Patil, M.G.; Pagare, J.; Patil, S.N.; Sidhu, A.K. Extracellular Enzymatic Activities of Endophytic Fungi Isolated from Various Medicinal Plants. Int. J. Curr. Microbiol. App. Sci. 2015, 4, 1035–1042. [Google Scholar]
- Schulz-Bohm, K.; Sánchez, M.L.; Garbeva, P. Microbial Volatiles: Small Molecules with an Important Role in Intra- and Inter-Kingdom Interactions. Front. Microbiol. 2017, 8, 2484. [Google Scholar] [CrossRef]
- Schmidt, R.; Jager, V.; Zühlke, D.; Wolff, C.; Bernhardt, J.; Cankar, K.; Beekwilder, J.; van Ijcken, W.; Sleutels, F.; de Boer, W.; et al. Fungal volatile compounds induce production of the secondary metabolite Sodorifen in Serratia plymuthica PRI-2. Sci. Rep. 2017, 7, 862. [Google Scholar] [CrossRef] [PubMed]
- Kaddes, A.; Fauconnier, M.L.; Sassi, K.; Nasraoui, B.; Jijakli, M.H. Endophytic Fungal Volatile Compounds as Solution for Sustainable Agriculture. Molecules 2019, 24, 1065. [Google Scholar] [CrossRef]
- Diby, P.; Park, K.S. Dentification of Volatiles Produced by Cladosporium cladosporioides CL-1, a Fungal Biocontrol Agent That Promotes Plant Growth. Sensors 2013, 13, 13969–13977. [Google Scholar] [CrossRef]
- Kumla, J.; Suwannarach, N.; Matsui, K.; Lumyong, S. Biosynthetic pathway of indole-3-acetic acid in ectomycorrhizal fungi collected from northern Thailand. PLoS ONE 2020, 15, e0227478. [Google Scholar] [CrossRef]
- Fu, S.F.; Wei, J.Y.; Chen, H.W.; Liu, Y.Y.; Lu, H.Y.; Chou, J.Y. Indole-3-acetic acid: A widespread physiological code in interactions of fungi with other organisms. Plant Signal. Behav. 2015, 10(8), e1048052. [Google Scholar] [CrossRef]
- Egamberdieva, D.; Wirth, S.J.; Alqarawi, A.A.; Abd Allah, E.F.; Hashem, A. Phytohormones and Beneficial Microbes: Essential Components for Plants to Balance Stress and Fitness. Front. Microbiol. 2017, 8, 2104. [Google Scholar] [CrossRef]
- Khan, A.L.; Hamayun, M.; Kang, S.M.; Kim, Y.H.; Jung, H.Y.; Lee, J.H.; Lee, I.J. Endophytic fungal association via gibberellins and indole acetic acid can improve plant growth under abiotic stress: An example of Paecilomyces formosus LHL10. BMC Microbiol. 2012, 12, 3. [Google Scholar] [CrossRef]
- Waqas, M.; Khan, A.L.; Lee, I.J. Bioactive chemical constituents produced by endophytes and effects on rice plant growth. J. Plant Interact. 2014, 9, 478–487. [Google Scholar] [CrossRef]
- Ku, Y.S.; Rehman, H.M.; Lam, H.M. Possible Roles of Rhizospheric and Endophytic Microbes to Provide a Safe and Affordable Means of Crop Biofortification. Agronomy 2019, 9, 764. [Google Scholar] [CrossRef]
- Adhikari, P.; Pandey, A. Phosphate solubilization potential of endophytic fungi isolated from Taxus wallichiana Zucc. roots. Rhizosphere 2019, 9, 2–9. [Google Scholar] [CrossRef]
- Lugtenberg, B.J.J.; Caradus, J.R.; Johnson, L.J. Fungal endophytes for sustainable crop production. FEMS Microbiol. Ecol. 2016, 92, fiw194. [Google Scholar] [CrossRef] [PubMed]
- Manganyi, M.C.; Ateba, C.N. Untapped Potentials of Endophytic Fungi: A Review of Novel Bioactive Compounds with Biological Applications. Microorganisms 2020, 8, 1934. [Google Scholar] [CrossRef] [PubMed]
- Omomowo, O.I.; Babalola, O.O. Bacterial and Fungal Endophytes: Tiny Giants with Immense Beneficial Potential for Plant Growth and Sustainable Agricultural Productivity. Microorganisms 2019, 7, 481. [Google Scholar] [CrossRef] [PubMed]

| Antagonistic Fungal Isolate | Inhibition * (%) | |||
|---|---|---|---|---|
| F. graminearum | B. allii | S. sclerotiorum | R. solani | |
| Cladosporium sp. T1 | 35.6 ± 0.5 | 37.1 ± 0.4 | 40.8 ± 0.9 | 35.5 ± 0.5 |
| Cladosporium sp. T2 | 57.4 ± 0.5 | 86.4 ± 0.5 | 62.6 ± 0.5 | 56.9 ± 0.9 |
| Cladosporium sp. T3 | 47.1 ± 0.4 | 58.3 ± 0.6 | 29.2 ± 0.4 | 41.7 ± 0.5 |
| Fungal Isolate | Growth Parameters * | ||||
|---|---|---|---|---|---|
| Total Weight (g) | Total Height (cm) | Plant Height (cm) | Root System Length (cm) | Number of Leaves | |
| Cladosporium sp. T1 | 0.06 ± 0.01 | 10.0 ± 0.3 | 7.5 ± 0.2 | 2.5 ± 0.2 | Two leaves of medium size |
| Cladosporium sp. T2 | 0.06 ± 0.01 | 10.5 ± 0.2 | 7.5 ± 0.4 | 3.5 ± 0.3 | Two leaves of medium size |
| Cladosporium sp. T3 | 0.06 ± 0.01 | 10.3 ± 0.3 | 6.8 ± 0.4 | 3.2 ± 0.2 | Two leaves of medium size |
| Control | 0.03 ± 0.01 | 7.5 ± 0.2 | 5.5 ± 0.2 | 2.0 ± 0.3 | Two leaves of small size |
| Culture Filtrate from Isolates | Colony Diameter (cm) * | ||
|---|---|---|---|
| Keratinase Activity | Chitinase Activity | Cellulase Activity | |
| Cladosporium sp. T1 (medium without feathers) | 0 | 0 | 0.6 ± 0.05 mm |
| Cladosporium sp. T1 (medium with feathers) | 2.6 ± 0.05 | 2.2 ± 0.1 | 2.2 ± 0.05 |
| Cladosporium sp. T2 (medium without feathers) | 0.7 ± 0.05 | 0.7 ± 0.1 | 0.6 ± 0.05 |
| Cladosporium sp. T2 (medium with feathers) | 4.3 ± 0.05 | 3.4 ± 0.09 | 3.1 ± 0.08 |
| Cladosporium sp. T3 (medium without feathers) | 0.6 ± 0.06 | 0.8 ± 0.05 | 0.8 ± 0.08 |
| Cladosporium sp. T3 (medium with feathers) | 3.2 ± 0.00 | 3.2 ± 0.05 | 2.4 ± 0.09 |
| Strain | DO*530 nm (PDB Medium) | DO*530 nm (PDB + L-Tryptophan) |
|---|---|---|
| Cladosporium T1 | 0.014 ± 0.001 | 0.024 ± 0.001 |
| Cladosporium T2 | 0.076 ± 0.002 | 0.125 ± 0.012 |
| Cladosporium T3 | 0.047 ± 0.001 | 0.102 ± 0.002 |
| Control (culture medium) | 0.010 ±0.002 | 0.014 ± 0.001 |
| Sample | Total Nitrogen * (Kjeldhal) (mg/mg) | Ammonium Nitrogen * (mg/mg) | Protein Nitrogen * (mg/mg) | |||
|---|---|---|---|---|---|---|
| Medium no Feathers | Medium with Feathers | Medium no Feathers | Medium with Feathers | Medium no Feathers | Medium with Feathers | |
| Cladosporium T1 isolate | 127 × 10−3 | 137 × 10−3 | 61 × 10−3 | 87 × 10−3 | 66 × 10−3 | 50 × 10−3 |
| Cladosporium T2 isolate | 90 × 10−3 | 569 × 10−3 | 93 ×10−3 | 211 × 10−3 | 55 × 10−3 | 358 × 10−3 |
| Cladosporium T3 isolate | 102 × 10−3 | 120 × 10−3 | 88 × 10−3 | 87 × 10−3 | 33 × 10−3 | nd |
| Minimal basal medium-Control | 80 × 10−3 | 96 × 10−3 | 60 × 10−3 | 84 × 10−3 | 20 × 10−3 | 12 × 10−3 |
| Protein Hydrolysates Obtained from Cladosporium Cultures Grown on Different Media | Stem Height * (cm) | Stem Weight * (g) | Root Weight * (g) |
|---|---|---|---|
| Isolate T1 (medium without feathers) | 8.48 ± 0.9 | 0.49 ± 0.09 | 0.06 ± 0.01 |
| Isolate T1P (medium with feathers) | 8.88 ± 0.9 | 0.48 ± 0.09 | 0.09 ± 0.02 |
| Isolate T2 (medium without feathers) | 8.62 ± 0.9 | 0.55± 0.08 | 0.07 ± 0.01 |
| Isolate T2P (medium with feathers) | 9.34 ± 0.7 | 0.65 ± 0.1 | 0.09 ± 0.03 |
| Isolate T3 (medium without feathers) | 8.33 ± 0.7 | 0.44 ± 0.08 | 0.07 ± 0.01 |
| Isolate T3P (medium with feathers) | 9.23 ± 0.9 | 0.51 ± 0.08 | 0.09 ± 0.03 |
| Minimal medium (MM) | 6.73 ± 0.8 | 0.38 ± 0.07 | 0.06 ± 0.02 |
| Control (water) | 6.37 ± 0.9 | 0.23 ± 0.07 | 0.04 ± 0.02 |
Publisher’s Note: MDPI stays neutral with regard to jurisdictional claims in published maps and institutional affiliations. |
© 2021 by the authors. Licensee MDPI, Basel, Switzerland. This article is an open access article distributed under the terms and conditions of the Creative Commons Attribution (CC BY) license (http://creativecommons.org/licenses/by/4.0/).
Share and Cite
Răut, I.; Călin, M.; Capră, L.; Gurban, A.-M.; Doni, M.; Radu, N.; Jecu, L. Cladosporium sp. Isolate as Fungal Plant Growth Promoting Agent. Agronomy 2021, 11, 392. https://doi.org/10.3390/agronomy11020392
Răut I, Călin M, Capră L, Gurban A-M, Doni M, Radu N, Jecu L. Cladosporium sp. Isolate as Fungal Plant Growth Promoting Agent. Agronomy. 2021; 11(2):392. https://doi.org/10.3390/agronomy11020392
Chicago/Turabian StyleRăut, Iuliana, Mariana Călin, Luiza Capră, Ana-Maria Gurban, Mihaela Doni, Nicoleta Radu, and Luiza Jecu. 2021. "Cladosporium sp. Isolate as Fungal Plant Growth Promoting Agent" Agronomy 11, no. 2: 392. https://doi.org/10.3390/agronomy11020392
APA StyleRăut, I., Călin, M., Capră, L., Gurban, A.-M., Doni, M., Radu, N., & Jecu, L. (2021). Cladosporium sp. Isolate as Fungal Plant Growth Promoting Agent. Agronomy, 11(2), 392. https://doi.org/10.3390/agronomy11020392

